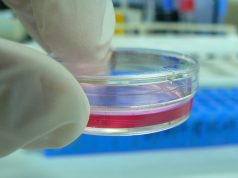
More health claims as FDA comes under pressure to be even tougher

Fergus Mason
Gap grows between New Zealand and USA, Australia as Kiwi government backs vaping
San Francisco vapers organise against ban
San Francisco’s notoriously anti-vaping Board of Supervisors seems determined to ban all e-cigarette sales within the city, both online...
More health claims as FDA comes under pressure to be even tougher
New study claims vape flavours cause heart attacks
A recently published paper from Stanford University in – where else? – the USA claims vaping, especially...
Health officials in Texas and California lose their minds; Washington vapers lose money
Houston, TX “Health” official caught lying to children
A so-called “health” official from Houston County has been touring schools in the Texas city, giving children...
State lawmakers balk at more anti-vaping laws, and JUUL hit back at dubious Twitter...
Arizona moves to protect vapers from kneejerk laws
In a rare show of opposition to the anti-vaping hysteria that’s currently sweeping the USA, Arizona lawmakers...
US fightback against vape taxes scores a hit
Think tank warns Alaska vape tax would protect smoking
The influential Heartland Institute has warned Alaska lawmakers that their proposed new sin tax on vapour...
Wins in Canada, losses in the USA – bad vape law keeps spreading
Quebec anti-vaping law watered down by judge
New anti-vaping laws in Quebec have been strongly criticised by harm reduction advocates. Now a judge has at...
Anti-vapers in USA keep up the pressure
Flavour ban moves forward in Senate with FDA support
Legislation that could ban all flavoured e-liquids across the USA is moving forward in the Senate,...
US vapers face national age limit hike, while state lawmakers push for more bans
US Congress pushes for nationwide T21 law
One of the more disturbing moves underway in the United States is the Tobacco 21 campaign, which aims...